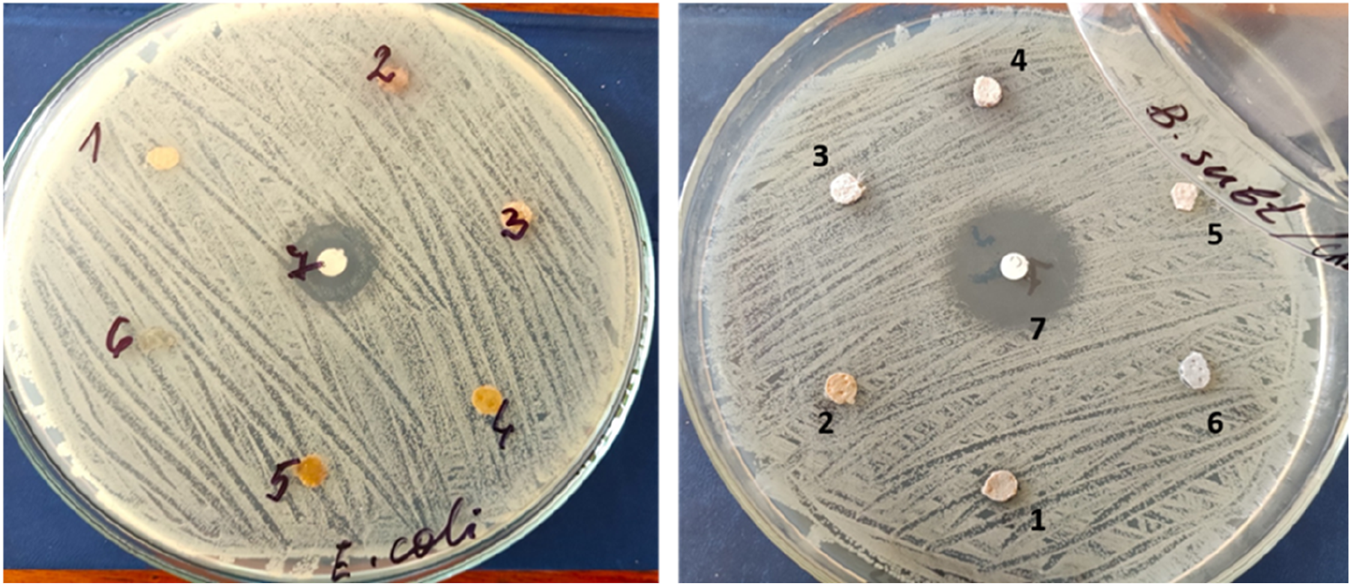
Two petri dishes with bacterial cultures and numbered discs for testing antimicrobial activity. The left dish is labeled "E. coli" with six discs, and the right dish is labeled "B. subtilis" with seven discs.
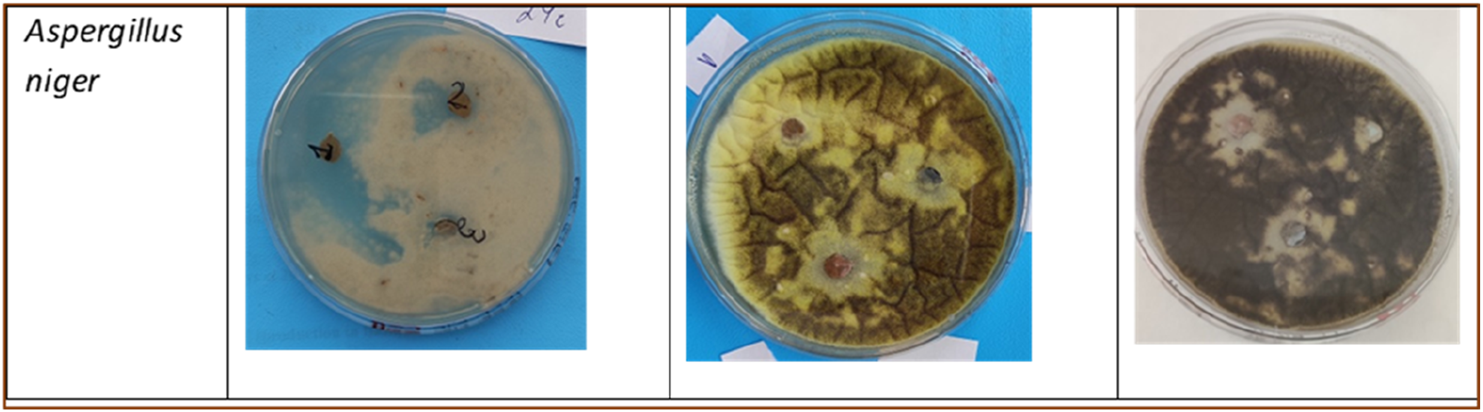
Three petri dishes displaying different growth stages of Aspergillus niger fungus. The first dish shows minimal growth with a light surface. The second dish exhibits moderate, yellow-brown growth with visible texture changes. The third dish shows dense, dark growth covering most of the surface.

Abstract
Prolonged wearing of shoes creates conditions for bacterial and fungal diseases. The use of nanotechnology and especially metal nanoparticles enables the production of high-quality leather for footwear with good antimicrobial properties. The pre-tanning process, which involves adding metal particles to the tanning solution, has been the subject of several studies on the application of metal oxides to leather. Few investigations have been conducted on the last finishing stage of leather nanoprocessing. The aim of the present study was to obtain and characterize the antimicrobial properties of finish films containing zinc oxide nanoparticles for shoe leather materials. The in situ method was applied to synthesize ZnO nanoparticles and these particles were deposited in a cross-linked collagen hydrogel applied to shoe lining materials. The obtained samples were examined by means of SEM, UV, FTIR and antimicrobial tests, and their properties were proven. Morphological analysis revealed the widespread presence of zinc oxide nanoparticles within the leather sample’s structure. Spectroscopic examinations highlighted the interactions between collagen in the leather tissue and gelatin on one side, while also detailing the bonds between inorganic particles on the other. The modified leather samples demonstrated a reduction in bacterial and fungal growth. The antimicrobial effectiveness varies depending on the type of modification and the specific bacterial strain tested. These finishes have been shown to serve as effective protective antimicrobial coatings for shoe leather materials, helping to safeguard the human foot from microbial exposure.
Introduction
Prolonged wearing of shoes creates conditions for fungal and bacterial diseases. The antibacterial treatment of materials based on natural leather and other materials inserted into the shoe is extremely important to protect the human foot from the attack of bacteria and fungi, which develop very quickly as a result of the appropriate microclimate in the shoe (increased humidity, temperature, various external pollution). Animal leather for shoe production, as an organic material, is a food source for various types of microorganisms, for example,: Genus Bacillus, Corynebacterium, Clostridium, Staphylococcus, Penicillium, Aspergillus, Paecilomyces, Candida, Cryptococcus (Oruko et al., 2019; Bielak et al., 2020). The effect of antibacterial agents is reduced to the destruction of microorganisms or the inhibition of their growth. This highlights the need to go beyond conventional tanning practices and consider antimicrobial strategies that ensure both durability and biological protection of leather materials. In addition to microbiological safety, it is becoming increasingly important to apply antimicrobial solutions that are environmentally friendly and do not lead to additional ecological burden. Some chemical antimicrobial agents are used in the tanning process, their main function is to prevent biodegradation of the leather, not to provide antimicrobial properties. In addition, the use of some antibacterial and antifungal agents is limited due to toxic effects on health and the environment. Therefore, it is extremely important for natural leather materials applicable to footwear to develop antimicrobial agents that are effective against a broad spectrum of bacterial and fungal strains and are environmentally friendly (Poles et al., 2019; Nawaz et al., 2011).
There are various methods for antibacterial treatment of leather for insole parts. Biosynthesized silver nanoparticles have been used as an antimicrobial agent for the treatment of pig leather by dip-drying processes (Healy et al., 2010; Thang et al., 2023). Researchers found that tanned leather with the addition of oils has antimicrobial activity against strains of E.coli, S.aureus and C.Albicans (Bielak and Syguła-Cholewińska, 2017).
Metals, metal salts, oxides and nanocomposite polycompounds possess certain activity against some well-known pathogenic microorganisms. The use of nanotechnology and especially metal nanoparticles enables the production of high-quality leather with good antibacterial properties (Muthukrishnan, 2021; Su et al., 2021). Much research has focused on the treatment of leather with nanometal oxides during the pre-tanning process, where nanomaterials are added to the tanning solution during leather treatment. There is still a limited amount of research deals with the nanoprocessing of leather in the final finishing step without adding the nanomaterial to the tanning solution. In the leather industry, nanotechnology is still in its infancy and has not yet reached widespread application (Vo et al., 2020; Carvalho et al., 2018; Staroń, A., and Długosz, O. 2021).
Among the various nanomaterials applied in the leather industry, zinc oxide (ZnO) stands out for its strong antimicrobial properties. Their positively charged particles can interact with the negatively charged surface of bacterial cell walls. Numerous studies have explored the application of metal oxides in leather treatment during the pre-tanning phase (Nawaz et al., 2011; Muthukrishnan, 2021). In contrast, research on nanoprocessing leather during the final finishing stage remains limited. The properties of metal nanoparticles and metal oxides such as TiO2, ZnO, Ag, and Cu determined them as an effective antimicrobial agents (Nguyen et al., 2023; Okhmat et al., 2024; Thang et al., 2023; Carvalho et al., 2018; Lkhagvajav et al., 2015; Ahmed et al., 2024). Zinc oxide nanoparticles (ZnO-NPs) have garnered significant interest from researchers due to their biocompatibility, non-toxic nature, and cost-effectiveness (Nawaz et al., 2011; Abebe, et al., 2020; Dey, et al., 2022; Jiang et al., 2015; Habib Mohamed and Manal Maher, 2023; Habib and Mulchandani, 2022; Gaidau et al., 2018; Bao, Y. et al., 2017; Vargas Hernández et al., 2024).
Traditional methods for preventing microbial growth in leather materials include the use of biocides (Bielak, et al., 2020). These preparations are largely hazardous to human health. A number of studies have focused on the use of metal oxides, for example,: TiO2, CuO, ZnO, as well as on combinations: CuO-ZnO, Ag-TiO2 (Vo et al., 2020; Carvalho et al., 2018; Soria-Castro et al., 2018). Various natural oils and dyes have also been studied in this context (Bielak and Syguła-Cholewińska, 2017).
This study aims to investigate the enhancing durability of leather lining materials by applying a finishing layer containing zinc oxide particles and to assay antimicrobial effectiveness of the modified materials. In our research, we applied the approach of depositing ZnO particles by in situ synthesis method onto pig tanned leather used for shoe linings. To fix the ZnO nanoparticles, we applied a cross-linked gelatin hydrogel, identical in structure to natural leather.
In the results of our investigations it was obtained new information about a new potential application of the ZnO NPs.
Materials and Methods
Materials
Natural, chrome-tanned pig leather for lining details, provided by a local manufacturer, without a finish coating, and with a thickness of 0.89 mm, was used. The evaluated samples had dimensions of 50/50 mm and an average weight of 2.3 g.
Gelatin from Merck KGaA (Darmstadt, Germany); Glutaraldehyde (25% aqueous solution) from Sigma-Aldrich (Darmstadt, Germany); Zn(NO3)2·6H2O (CAS:10,196-18-6) and NaOH were purchased from Sigma-Aldrich (Darmstadt, Germany). All solutions were prepared with distilled water.
Methods for Preparation of Composite Materials With ZnO
Figure 1 schematically presents the stages of modification of leather samples.
FIGURE 1

Flowchart illustrating a process of the composite materials preparation.
Method 1
Gelatin - crosslinking with glutaraldehyde; impregnation of leather (preliminary treated with oxalic acid) in solution of crosslinked gelatin; adding the solution of Zn(NO3)2.6H2O; adding the sodium hydroxide solution.
Method 2
Immersion of leather substrates in gelatin solution; adding the solution of Zn(NO3)2.6H2O; adding the glutaraldehyde as crosslinking agent; adding the sodium hydroxide solution.
Method 3 (an Ultrasound)
Impregnation of leather samples in gelatin solution; preparation of a solution of Zn(NO3)2·6H2O and NaOH solution and mixing; impregnation of leather–gelatin samples in solution of Zn(NO3)2.6H2O and NaOH; crosslinking by glutaraldehyde.
In our previous work, we investigated the synthesis and deposition of TiO2 in coatings for leather materials (Angelova et al., 2024). Based on these studies, in the present study we developed methods for the synthesis and incorporation of ZnO nanoparticles into finishing coatings for leather. Many of the analyses were similarly applied to the new composite materials.
Details regarding the preparation, mixing regimes, and processing conditions are presented in Table 1.
TABLE 1
| Method/Sample code | Solutions C, % | Process steps | Processing conditions |
|---|---|---|---|
| Le_ZnO-1 | Н2С2О4 (pretreatment): 2% w/v Gelatin: 5% w/v Glutaraldehyde: 2.5% w/w to gelatin Zn(NO3)2·6H2O (0.1M) NaOH: (10×excess vs. Zn2+) |
|
|
| Le_ZnO-2 | Н2С2О4 (pretreatment): 2% w/v Gelatin: 5% w/v Glutaraldehyde: 2.5% w/w to gelatin Zn(NO3)2·6H2O (0.1M) NaOH: (10× excess vs. Zn2+) |
|
|
| Le_ZnO-3 (ultrasonic bath) | Gelatin: 5% w/v Zn(NO3)2·6H2O (0.1M) NaOH: (10× excess vs. Zn2+) glutaraldehyde: 2.5% w/w to gelatin |
|
|
Methods and processing conditions for biocomposite materials Leather/Gelatin/ZnO.
Methods with varying the sequence of the crosslinking agent and addition of the components were previously designed to compare how the processing order affects nanoparticle deposition, coating stability, and antimicrobial properties. This approach allows us to determine the most effective way to achieve durable ZnO coatings on leather.
Analyses
Morphological Analysis
Samples were observed by using an inverted microscope Metaval (Carl Zeiss, Germany) operated in the dark-field mode with Planachromat-HD objectives (with magnification from 5x to 50x) and halogen light illumination (12V, 50W).
The surface morphology of the modified leather samples was analyzed with a Philips ESEM XL30 FEG SEM. Using SEM, the size, shape, and distribution of nanoparticles can be determined, as well as elemental quantitative and qualitative analysis can be performed in the 1 μm3 region.
FTIR Analysis
FTIR analysis was performed on a Fourier transform infrared spectrometer (IRAffinity-1, Shimadzu, Japan) equipped with a diffuse reflectance sphere (MIRacle Attenuated Total Reflectance Attachment), the spectral range of 4000 ÷ 600 cm−1.
UVA–VIS-NIR Transmittance Spectral Analysis
A spectrophotometer (UVA/VIS/NIR Lambda 750S, Perkin Elmer, USA) was used to perform the analysis, which covered the wavelength range of: λ from 2000 to 250 nm.
Antimicrobial Analysis
The antibacterial effect of the tested composite samples was evaluated by Kirby–Bauer method (Hudzicki, J., 2009). The selected bacterial strains used in this study included Pseudomonas aeruginosa 1390 (Gram-), Bacillus subtilis 168 (Gram+), Escherichia coli W 1655 (Gram-) from the National Bank of Industrial Microorganisms and Cell Cultures, Bulgaria, and Erysipelothrix rhusiopathiae B40 (Gram+) from the Institute of Microbiology (Angelova et al., 2024). Bacterial cultures were first grown overnight in Nutrient Broth (HIMedia, India) at 37 °C, and the cell density was then standardized to McFarland 0.5 (approximately 1.5 × 108 CFU/mL), according to CLSI guidelines (CLSI, 2012). Sterile Mueller-Hinton agar plates were inoculated with the standardized bacterial suspensions. Antibiotics were used as a positive control. Antimicrobial activity was determined after incubation for 24 h at 37 °C. Measurements were made of the diameter (mm) of the zones of inhibition (ZOI) around each disk (Balouiri et al., 2016).
The antifungal activity of the tested compounds was evaluated using the disc diffusion method. The test fungal strains used in this study included Aspergillus niger, Aspergillus fumigatus, and Candida albicans belonging to Mycological collection of the Stephan Angeloff Institute of Microbiology, BAS. Fungal strains were grown on Potato Dextrose Agar (HIMedia Laboratories Pvt. Ltd., Maharashtra, India) at 28 °C for 7 days to allow for adequate diffusion of the compounds and fungal growth. Spore suspension was prepared at concentration of 1 × 108 conidia/mL, and used for the investigation. The antifungal activity was determined at every 24 h of incubation by measuring the diameter (mm) of the inhibition zones around each disc, which appeared as clear areas.
Statistical Analysis
All experiments were performed in a minimum of triplicate to ensure reproducibility and reliability of the results. Data are expressed as mean values ±standard error (SE).
Results and Discussion
Morphological Properties of Leather Composites With ZnO
Figure 2 shows micrographs of pure leather samples with a distinct fibrous structure. Figure 3 presents microscopic images of samples obtained by method 1 (Le_ZnO-1). It is evident that the leather sample is coated with cross-linked gelatin, with Zn-NPs impregnated into the hydrogel structure. The microscopic ivestigations of the these samples reveal that the nanoparticles ZnO have transitioned fom spherical to flower-like structures, indicating that the nucleation of ZnO crystal structures has commenced on the leather surface. Clustering and agglomeration of ZnO particles is observed at specific locations in the leather matrix and these particles change from nano-size (from 50 to 200 nm for single psrticles) to micro-size (above 500 nm and above 1 μm for clusters). This agglomeration of particles is likely to have a more significant effect due to the larger surface area of ZnO. In Figure 4 the modified leather samples Le_ZnO-2 show a different morphological structure. The ZnO particles again form a flower-like structure, they also form agglomerates, but are situated on the hydrogel’s surface, suggesting they display higher activity.
FIGURE 2

Micrograph of pure leather sample (Le) (x20) and SEM.
FIGURE 3

Micrograph of modified leather (Le_ZnO-1) and SEM at different magnifications.
FIGURE 4

Micrograph of modified leather (Le_ZnO-2) and SEM at different magnifications.
Some authors have proposed an explanation mechanism for the in situ growth of ZnO nanostructures (Souza, D. et al., 2018). Their research shows that at the beginning of the reaction in the sol-chemical solution, few ZnO nuclei and many growth units are present. When the fabrics are immersed in this solution for shorter residence times (0 h and 1 h), the ZnO nuclei immediately adhere to the fiber surface and the large amount of growth units around these nuclei leads to rapid growth of ZnO particles. And in our study, similar phenomena are most likely observed, i.e., for the nucleation and crystal formation processes.
The formation of the observed “flower-like structures” can be explained by heterogeneous nucleation of ZnO nanoparticles on gelatin matrices. Functional groups such as amino and carboxyl act as binding sites for Zn2+ions, initiating localized nucleation. Upon addition of NaOH, supersaturation drives crystal growth along specific wurtzite planes, while the organic matrix restricts orientation and promotes radial assembly. This confinement results in the characteristic flower-like morphology. Recent studies confirm similar mechanisms (Nichelson, A., et al., 2025) reported that surfactant-assisted and sonochemical synthesis promoted the self-assembly of ZnO into flower-petal morphologies, highlighting the role of organic matrices and solution conditions in directing growth (Wang, Y. et al., 2016).
Elemental Analyses
Elemental analysis shows the presence of Zn in an amount reported on this area of 1 μm3. A Figure 5 present the elemental analysis of pure leather (Figure 5a), and modified leathers (Figures 5b, c). Elemental analysis of the modified leather samples shows that in sample Le_ZnO-1 (Figure 5b) there is about 11.6 wt. % of ZnO into the gelatin hydrogel, while in sample Le_ZnO-2 (Figure 5c) there is approximately 64.6 wt. % of per μm3 area. In sample Le_ZnO-2, the area is most likely coated with agglomerated ZnO particles, as well as SEM analyses prove the location of the zinc particles on the gelatin surface, showing the highest activity. The results fully correlate with the results for the antimicrobial activity.
FIGURE 5

(a) Elemental analyses of pure leather (Le). (b) Elemental analyses of modified leather (Le_ZnO-1). (c) Elemental analyses of modified leather (Le_ZnO-2).
FTIR Analyses
On Figure 6 are presented spectrum of analized samples.
FIGURE 6

FTIR analyses of pure and modified leather samples.
Absorption peaks (cm-1) of the FTIR spectrum: 3308, 2,924, 2,852, 1,647, 1,558, 1,456, 1,234, 1,033 cm-1 were assigned to–NH, –CH3, =CH2, –C=O, –NH, –C=O (in amide III) and C–N (in amine) groups. The collagen macromolecules in the leather and in the gelatin hydrogel contain polar groups in the side chains of their constituent amino acid residues, which are amino or amide groups and carboxyl groups, and can bind to metal atoms. The presence of Zn particles with the positive charge of zinc ions (Zn+) on the leather surface can interact electrostatically with the negative charge of the carboxylate residue (RCOO−) or with lone pair electrons of N atoms of amino acids (Sirelkhatim et al., 2015).
The peak at 852 cm-1 confirms the formation of tetrahedral coordination of ZnO (Jain et al., 2020). This peak is present in our spectra and these peaks are most clearly expressed in the composite obtained by Method 3 (Le_ZnO-3).
UV–VIS Absorbance Spectral Analysis
The UV-VIS absorption spectral analysis of the modified leather material is presented on Figure 7. The bands confirm the conclusions drawn from FTIR analysis about the collagen structure of the gelatin hydrogel and the leather, about the bonds with the crosslinking agent. But most indicative is the appearance of a low peak at 363 nm, which is an evident of the formation of nano ZnO.
FIGURE 7

UV–VIS analysis of pure and modified samples. Spectral graph display three transmission spectra labeled 1‐Le, 2‐Le_ZnO‐1, and 3‐Le_ZnO‐2, representing samples used in the study.
Antibacterial Properties of Leather Samples With Incorporated ZnO Particles
The antimicrobial activity of the tested leather samples was evaluated using the Kirby–Bauer disc diffusion method. The test bacterial strains used in this study included Pseudomonas aeruginosa (−), Bacillus subtilis (+), Escherichia coli (−) and Erysipelothrix rhysiopatiae (Gram+). Sterile Mueller-Hinton agar plates were inoculated with the standardized bacterial suspensions. The antimicrobial activity was determined after 24 h of incubation by measuring the diameter (mm) of the inhibition zones around each disc, which appeared as clear, bacteria-free areas.
As could be seen in Table 2 and Figure 8 the samples Le_ZnO-3 exhibits the highest bactericidal effect on Gram-positive spore-forming strain (B. subtillis).
TABLE 2
| Samples | Diameter of zones of inhibition (mm) | |||
|---|---|---|---|---|
| E. coli | P. aeruginosa | B. subtillis | E. rhysiopatiae | |
| Le (pure leather) | – | – | – | – |
| Le + gelatin | − | − | − | − |
| Le_ZnO-1 | – | – | – | – |
| Le_ZnO-2 | – | – | – | – |
| Le_ZnO-3 | – | – | 4 ± 1 | – |
| Positive control (antibiotic) | 7 ± 1.2 | 17 ± 1.1 | 18 ± 1.4 | 10 ± 0.9 |
Antibacterial activity of composite materials with ZnO on different bacterial strains.
There is no clear inhibition zone (−); Data are expressed as mean value ±standard error (SE).
FIGURE 8
Photo documentation of Antibacterial Activity of Composite Materials with ZnO on Gram+ (B. subtilis) and Gram- (E.coli) bacterial strains. 1 - Le (pure leather), 2 - Le_ZnO-1; 3 - Le_ZnO-2; 4 - Le_ZnO-3; 5 - empty paper disc; 6- paper disc with gelatin; 7- positive control (antibiotic).
After 24 h of aerobic cultivation of test microorganisms in termostate, presense or absence of inhibitory zones were observed. Performed experiments showed that Gram-positive (B. subtillis) bacteria is more sensitive to the samples with ZnO particles than tested Gram-negative bacteria (E. coli and P.aeruginosa). Our findings align with those reported by previous researchers, demonstrating similar trends in antibacterial performance. For example, in a study conducted by Emami-Karvani and Chehrazi (2011), it was shown that Gram-negative bacteria (E. coli) are more resistant to ZnO nanoparticles than Gram-positive bacteria (S. aureus). Similar results were also previously published by Reddy et al. (2007). Some scientists suggest that the higher sensitivity of Gram-positive bacteria may be related to differences in cell wall structure, cellular physiology, or metabolism. Additionally, variations in surface charge and cell membrane composition could influence the extent to which nanoparticles interact with cells (Girma et al., 2024).
Nanoparticles can damage cells in two ways: indirectly by generating reactive oxygen species (ROS), and directly by disrupting membrane integrity, penetrating the cytoplasm or interfering with essential processes such as proton pump activity.
The relatively low antibacterial activity observed in this study may be attributed to the limited diffusion of active ZnO particles from the impregnated leather samples, which restricts their availability at the site of bacterial interaction (Sukhodub et al., 2024; Zhang et al., 2008). Despite this, zinc oxide nanoparticles (ZnO-NPs) are well known for their strong antimicrobial properties, primarily due to their ability to generate (ROS) such as hydrogen peroxide, superoxide anions, and hydroxyl radicals, which cause oxidative stress and damage to bacterial cells. Additionally, the release of Zn2+ ions from ZnO-NPs interferes with bacterial metabolism and enzyme function, while their small size allows them to effectively penetrate bacterial membranes (Bouttier-Figueroa, et al., 2024). They can also interact with intracellular components, leading to structural or functional damage, including to DNA. The effect of nanoparticles depends on their physicochemical characteristics, such as size, shape, surface charge and hydrophobicity. This phenomenon provides a practical way to modulate and optimise their antimicrobial activity against different bacterial groups (Rahman et al., 2024).
Antifungal Activity Test
The antifungal activity of the tested compounds was evaluated using the disc diffusion method as well. The test fungal strains used in this study included Aspergillus niger, Aspergillus fumigatus, and Candida albicans. Fungal strains were grown on Potato Dextrose Agar at 28 °C for 7 days.
Modified leather samples show excellent protective effects against fungal strains Aspergillus niger and Candida albicans compared to untreated leather samples, which did not exhibit any antifungal activity (Table 3; Figure 9).
TABLE 3
| | Samples | Fungal strains | ||||||
|---|---|---|---|---|---|---|---|---|
| Aspergillus fumigatus | Aspergillus niger | Candida albicans | ||||||
| 24–72 h | 24 h | 48 h | 72 h | 24 h | 48 h | 72 h | ||
| 1 | Le_ZnO-1 | − | + | Inhibits sporulation | Inhibits sporulation | + | + | − |
| 2 | Le_ZnO-2 | − | + | Inhibits sporulation | Inhibits sporulation | + | − | − |
| 3 | Le_ZnO-3 | − | + | Inhibits sporulation | Inhibits sporulation | + | − | − |
| 4 | Le | − | − | − | − | − | − | − |
| 5 | Le + gelatin | − | − | − | − | − | − | − |
Antifungal activity test.
There is no inhibition zone (−); growth inhibition (+).
FIGURE 9
Antifungal activity of composite materials with ZnO against Aspergillus niger. after 24, 48 and 72 h of treatment.
Our results show that the three modified variants inhibit the growth of Candida albicans for 24 h, after which the fungal strain resumes its growth. In Aspergillus niger, inhibition of fungal growth is again observed for 24 h, followed by suppression of sporulation for up to 72 h (Table 3; Figure 9).
Some authors reported that chemically synthesized ZnO nanoparticles exhibit significant antifungal activity against Colletotrichum sp., Erythricium salmonicolor, and Cercospora coffeicola. Although their mechanism of action is not yet fully understood, it is suggested to involve both physical and chemical processes. The physical mechanisms depend on the size and surface properties of the nanoparticles and may disrupt ion and electron transport, membrane integrity, and protein function. The chemical mechanisms include the generation of reactive oxygen species (ROS), ion release through efflux, and direct interaction with the cell membrane, leading to oxidative stress and impaired permeability (Subba et al., 2024).
Upon treatment with ZnO-NPs, compact vacuole-like structures were observed within the hyphae, accompanied by a reduction in cytoplasmic volume. A layer of electron-dense particles formed around the cell wall, likely reflecting the adsorption of ZnO-NPs - a process frequently reported in nanoparticle–cell interactions. Alterations in the physicochemical properties of nanoparticles can lead to disrupted enzyme activity, damage to the cell membrane, impaired nutrient uptake, and genotoxic effects (Mosquera-Sanchez and Arciniegas-Grijalba, 2020).
The reduced antimicrobial activity is likely attributable to the limited diffusion of zinc ions resulting from the crosslinking of gelatin.
Zinc oxide nanoparticles (ZnO-NPs) show strong antibacterial potential against both Gram-positive and Gram-negative bacteria. The antibacterial activity of ZnO-NPs is still under investigation, but research suggests several possible mechanisms. These include direct interaction with bacterial cell surfaces, leading to membrane disruption; the generation of reactive oxygen species (ROS) on the ZnO-NPs surface; and the dissolution of particles, releasing free Zn2+ ions. The latter process disturbs cellular zinc ion balance, increasing ROS levels and ultimately causing cell damage and necrosis. It is likely that the antibacterial effects result from a combination of these pathways (Raha and Ahmaruzzaman, 2022). The antifungal activity of ZnO nanoparticles synthesized from E. crassipes extract was established against fungal strains isolated from building materials, including Aspergillus sp., Stachybotrys sp., Fusarium sp. and Phoma sp. Higher concentrations exhibited a stronger antifungal effect, probably due to the larger polydispersity index (PDI) and crystallite sizes.
Given the potential interaction of zinc nanoparticle coatings with human skin, it is essential to evaluate the toxicological implications of zinc ion release and comprehensively assess the safety profile of the proposed technology. Zinc oxide nanoparticles (ZnO-NPs) have been widely investigated due to their broad applicability and are generally considered safe at low concentrations, with GRAS (Generally Recognized As Safe) status granted for certain uses (Hou, J., et al., 2018). Nevertheless, their nanoscale dimensions and enhanced surface reactivity warrant careful toxicological and regulatory evaluation. While most studies to date report limited dermal penetration and low acute toxicity in humans, the long-term effects of chronic exposure, remain insufficiently understood. Since the early 2000s, the safety of nanomaterials has been a central focus of scientific and regulatory discourse, underscoring the need for comprehensive risk assessments that integrate (Fernández-Bertólez, et al., 2024; Casiano-Muñiz and Ortiz-Román, 2024). Nanomaterials fall under the scope of EU regulatory mechanisms (REACH- Registration, Evaluation, Authorisation and Restriction of Chemicals (REACH), establishing a European Chemicals Agency) (https://echa.europa.eu/regulations/reach). In this context, future research should aim to bridge existing knowledge gaps by combining in vitro, in vivo, and computational approaches, thereby ensuring that the benefits of ZnO nanotechnology are realized without compromising human health or environmental safety.
Conclusion
A modification of natural leather was carried out with an application for lining details of the shoe. A finish coating was successfully obtained by modifying leather samples with cross-linked gelatin containing ZnO particles, which particles were synthesized in situ. Microscopic studies showed that ZnO-NPs were impregnated into the hydrogel structure of the gelatin and were distributed into small film-forming structures. Spherical particles of ZnO nanoparticles changed into a flower-like shape, indicating that the nucleation of ZnO crystal structures had started on the leather surface.
The ZnO-NPs modified leather samples showed better activity against the Gram-positive than Gram-negative bacteria and were excellent protective effects against fungal strains Aspergillus niger and Candida albicans compared to untreated leather samples, which did not exhibit any antifungal activity.
It has been found that these finishes can be very effectively used as protective antibacterial and antifungal coatings for shoe leather materials, protecting the human foot from the effects of microorganisms.
However, the wider application of such specialized functional coatings remains limited by unresolved challenges related to the recovery and end-of-life management of embedded nanoparticles. Currently, technologies capable of extracting or regenerating these particles from materials used in the footwear or leather industry are not yet available, which constrains both their sustainable reuse and their safer long-term application.
Statements
Data availability statement
The datasets presented in this article are not readily available because no restrictions. Requests to access the datasets should be directed to darinajeleva@abv.bg.
Author contributions
All authors listed have made a substantial, direct, and intellectual contribution to the work and approved it for publication.
Funding
The author(s) declared that financial support was received for this work and/or its publication. This study is funded by the European Union-Next Generation EU, through the National Recovery and Resilience Plan of the Republic of Bulgaria, project No. BG-RRP-2.004-0002 C01, “BiOrgaMCT”.
Acknowledgments
This study is funded by the European Union-Next Generation EU, through the National Recovery and Resilience Plan of the Republic of Bulgaria, project No. BG-RRP-2.004-0002 C01, “BiOrgaMCT”.
Conflict of interest
The author(s) declared that this work was conducted in the absence of any commercial or financial relationships that could be construed as a potential conflict of interest.
Generative AI statement
The author(s) declared that generative AI was not used in the creation of this manuscript.
Any alternative text (alt text) provided alongside figures in this article has been generated by Frontiers with the support of artificial intelligence and reasonable efforts have been made to ensure accuracy, including review by the authors wherever possible. If you identify any issues, please contact us.
References
1
Abebe B. Zereffa E. A. Tadesse A. Ananda Murthy H. C. (2020). A Review on Enhancing the Antibacterial Activity of ZnO: Mechanisms and Microscopic Investigation. Nanoscale Res. Lett.15, 190. 10.1186/s11671-020-03418-6
2
Ahmed S. Imon S. S. Hasan M. , J. Md S. (2024). Green Nanotechnology for the Enhancement of Antibacterial Properties in Lining Leather: Mgo-Chitosan Nanocomposite Coating. Heliyon10 (20), e39170. 10.1016/j.heliyon.2024.e39170
3
Angelova D. S. Zheleva D. Gocheva Y. Krumova E. (2024). “Antibacterial Coating for Shoe Insoles with Titanium Dioxide Nanoparticles,” in ICAMS Proceedings of the International Conference on Advanced Materials and Systems, 17–23. 10.2478/9788367405805-002
4
Balouiri M. Sadiki M. Ibnsouda S. K. (2016). Methods for In Vitro Evaluating Antimicrobial Activity: A Review. J. Pharm. Analysis6 (2), 71–79. 10.1016/j.jpha.2015.11.005
5
Bao Y. Feng C. Wang C. Ma J. Tian C. (2017). Hygienic, Antibacterial, UV-Shielding Performance of Polyacrylate/ZnO Composite Coatings on a Leather Matrix. Colloids Surfaces A Physicochem. Eng. Aspects518, 232–240. 10.1016/j.colsurfa.2017.01.033
6
Bielak E. Syguła-Cholewińska J. (2017). Antimicrobial Effect of Lining Leather Fatliquored with the Addition of Essential Oils. Biotechnol. Food Sci.81 (2), 149–157. Available online at: http://www.bfs.p.lodz.pl/ (Accessed December 13, 2017).
7
Bielak E. Marcinkowska E. Syguła-Cholewińska J. (2020). Investigation of Finishing of Leather for Inside Parts of the Shoes with a Natural Biocide. Sci. Rep.10, 3467. 10.1038/s41598-020-60285-y
8
Bouttier-Figueroa D. C. Cortez-Valadez M. Flores-Acosta M. Robles-Zepeda R. E. (2024). Green Synthesis of Zinc Oxide Nanoparticles Using Plant Extracts and Their Antimicrobial Activity. Bionanoscience14 (3), 3385–3400. 10.1007/s12668-024-01471-4
9
Carvalho I. Ferdov S. Mansilla C. Marques S. Cerqueira M. Pastrana L. et al (2018). Development of Antimicrobial Leather Modified with Ag–TiO2 Nanoparticles for Footwear Industry. Sci. Technol. Mater.30, 60–68. 10.1016/j.stmat.2018.09.002
10
Casiano-Muñiz I. Ortiz-Román M. Lorenzana-Vázquez G. Román-Velázquez F. R. (2024). Synthesis, Characterization, and Ecotoxicology Assessment of Zinc Oxide Nanoparticles by in Vivo Models. Nanomaterials14, 255. 10.3390/nano14030255
11
CLSI (2012). Methods for Dilution Antimicrobial Susceptibility Tests for Bacteria that Grow Aerobically, Approved Standard. 9th ed. Wayne, PA, USA: Clinical and Laboratory Standards Institute. CLSI document M07-A9.
12
Dey T. Kumar H. Jamal A. Layek R. K. Uddin M. E. (2022). Zinc Oxide Nanoparticle Reinforced Waste Buffing Dust Based Composite Insole and its Antimicrobial Activity. Adv. Polym. Technol.2022, 1–10. 10.1155/2022/7130551
13
Emami-Karvani Z. Chehrazi P. (2011). Antibacterial Activity of ZnO Nanoparticle on Gram-Positive and Gram-Negative Bacteria. Afr. J. Microbiol. Res.5, 1368. 10.5897/AJMR10.159
14
Fernández-Bertólez N. Alba-González A. Touzani A. Ramos-Pan L. Méndez J. Reis A. T. et al (2024). Toxicity of Zinc Oxide Nanoparticles: Cellular and Behavioural Effects. Chemosphere363, 142993. 10.1016/j.chemosphere.2024.142993
15
Gaidau C. Ignat M. Vidiu Iordache O. Madalina Popescu L. Piticescu R. M. Ditu L. M. et al (2018). ZnO Nanoparticles for Antimicrobial Treatment of Leather Surface. REV.CHIM. Buchar.69 (4), 767–771. 10.37358/rc.18.4.6197
16
Girma A. Mebratie G. Mekuye A. B. Bekele B. Alamnie G. (2024). Antibacterial Capabilities of Metallic Nanoparticles and Influencing Factors. Nano Sel.5, e202400049. 10.1002/nano.202400049
17
Habib M. A. Mulchandani N. (2022). Adding Value to Sheep Leather via Coating with Green Synthesized Zinc Oxide Nanoparticles: Approaches for Advanced Leather Products. SLTC J.106, 264. Available online at: researchgate.net/publication/368510969_Adding_Value_to_Sheep_Leather_via_Coating_with_Green_Synthesised_Zinc_Oxide_Nanoparticles_Approaches_for_Advanced_Leather_Products.
18
Habib Mohamed A. Manal Maher H. (2023). Antimicrobial Performance of Sole Leather Loaded with Zinc Oxide Nanoparticle. J. Nat. Fibers20 (2), 2226415. 10.1080/15440478.2023.2226415
19
Healy A. Dunning D. N. Chockalingam N. (2010). Materials Used for Footwear Orthoses: A Review. Footwear Sci.2, 93–110. 10.1080/19424280.2010.486045
20
Hou J. Wu Y. Li X. Wei B. Li S. Wang X. (2018). Toxic Effects of Different Types of Zinc Oxide Nanoparticles on Algae, Plants, Invertebrates, Vertebrates and Microorganisms. Chemosphere193, 852–860. 10.1016/j.chemosphere.2017.11.077
21
Hudzicki J. (2009). Kirby-Bauer Disk Diffusion Susceptibility Test Protocol. Washington, DC: American Society for Microbiology. Available online at: https://www.asm.org/Protocols/Kirby-Bauer-Disk-Diffusion-SusceptibilityTest-Pro (Accessed December 08, 2009).
22
Jain D. Bhojiya Shivani A. A. Singh H. Daima H. K. Singh M. et al (2020). Microbial Fabrication of Zinc Oxide Nanoparticles and Evaluation of Their Antimicrobial and Photocatalytic Properties. Front. Chem.8, 778. 10.3389/fchem.2020.00778
23
Jiang Y. O’Neill A. J. Ding Y. (2015). Zinc Oxide Nanoparticle-Coated Films: Fabrication, Characterization, and Antibacterial Properties. J. Nanoparticle Res.17 (4), 180. 10.1007/s11051-015-2993-6
24
Lkhagvajav N. Koizhaiganova M. Yasa I. Çelik E. Sari Ö. (2015). Characterization and Antimicrobial Performance of Nano Silver Coatings on Leather Materials. Braz. J. Microbiol.46, 41–48. 10.1590/S1517-838220130446
25
Mosquera-Sánchez L. P. Arciniegas-Grijalba P. A. Patiño-Portela M. Guerra–Sierra B. Muñoz-Florez J. Rodríguez-Páez J. (2020). Antifungal Effect of Zinc Oxide Nanoparticles (ZnO-NPs) on Colletotrichum Sp., Causal Agent of Anthracnose in Coffee Crops. Biocatal. Agric. Biotechnol.25, 101579. 10.1016/j.bcab.2020.101579
26
Muthukrishnan L. (2021). Nanotechnology for Cleaner Leather Production: A Review. Environ. Chem. Lett.19, 2527–2549. 10.1007/s10311-020-01172-w
27
Nawaz H. R. Solangi B. A. Zehra B. Nadeem U. (2011). Preparation of Nano Zinc Oxide and Its Application in Leather as a Retanning and Antibacterial Agent. Can. J. Sci. Industrial Res.2 (4), 164–170. Available online at: researchgate.net/publication/324496022_Preparation_of_Nano_Zinc_Oxide_and_its_Application_in_Leather_as_a_Retanning_and_Antibacterial_Agent_Preparation_of_Nano_Zinc_Oxide_and_its_Application_in_Leather_as_a_Retanning_and_Antibacterial_Agen.
28
Nguyen N.-T. Vu T.-H. Bui V.-H. (2023). Antibacterial and Antifungal Fabrication of Natural Lining Leather Using Bio-Synthesized Silver Nanoparticles from Piper betle L. Leaf Extract. Polymers15 (12), 2634. 10.3390/polym15122634
29
Nichelson A. Kumar P. R. Kamarulazam F. Pershaanaa M. Ramesh K. Ramesh S. (2025). Tailoring ZnO Nanomaterials with Flower Morphology for Supercapacitors Application. Ionics31, 4885–4900. 10.1007/s11581-025-06215-2
30
Okhmat O. Mokrousova O. Pysarenko P. (2024). “Potential of Silver Nanoparticles in Imparting Antimicrobial Properties to Leather,” in Proceedings of THE 10th International Conference on Advanced Materials and Systems ICAMS 2024 (Bucharest), 162. 10.2478/9788367405805-fm
31
Oruko R. O. Odiyo J. N. Edokpayi J. (2019). The Role of Leather Microbes in Human Health. Role of Microbes in Human Health and Diseases. Intech Open. 10.5772/intechopen.81125
32
Poles E. Polissi A. Battaglia A. Giovando S. Gotti M. (2019). Study on the Antibacterial Properties of Leathers Tanned with Natural Tannins and Their Interactions with Shoes Inhabiting Bacteria. J. of AQEIC70 (2), 22–31.
33
Raha S. Ahmaruzzaman M. (2022). ZnO Nanostructured Materials and Their Potential Applications: Progress, Challenges and Perspectives. Nanoscale Adv.4 (8), 1868–1925. 10.1039/d1na00880c
34
Rahman S. Sadaf S. Hoque M. E. Mishra A. Mubarak N. M. Malafaia G. et al (2024). Unleashing the Promise of Emerging Nanomaterials as a Sustainable Platform to Mitigate Antimicrobial Resistance. RSC Advances14 (20), 13862–13899. 10.1039/d3ra05816f
35
Reddy K. M. Feris K. Bell J. Wingett D. G. Hanley C. Punnoose A. (2007). Selective Toxicity of Zinc Oxide Nanoparticles to Prokaryotic and Eukaryotic Systems. Appl. Phys. Lett.90, 2139021–2139023.84. 10.1063/1.2742324
36
Sirelkhatim A. Mahmud S. Seeni A. Kaus N. H. M. Ann L. C. Bakhori S. K. M. et al (2015). Review on Zinc Oxide Nanoparticles: Antibacterial Activity and Toxicity Mechanism. Nanomicro Lett.7 (3), 219–242. 10.1007/s40820-015-0040-x
37
Soria-Castro M. De La Rosa-García S. Quintana P. (2018). Broad Spectrum Antimicrobial Activity of Ca(Zn(OH)3)2.2H2O and ZnO Nanoparticles Synthesized by the sol–gel Method. J. Sol-Gel. Sci. Technol.89, 284–294. 10.1007/s10971-018-4759-y
38
Souza D. A. R. Gusatti M. Ternus R. Z. Fiori M. A. Riella H. G. (2018). In Situ Growth of ZnO Nanostructures on Cotton Fabric by Solochemical Process for Antibacterial Purposes. J. Nanomater.2018, 1–9. 10.1155/2018/9082191
39
Staroń A. Długosz O. (2021). Antimicrobial Properties of Nanoparticles in the Context of Advantages and Potential Risks of Their Use. J. Environ. Sci. Health, Part A56 (6), 680–693. 10.1080/10934529.2021.1917936
40
Su Y. Pengyu Li Dangge G. Bin L. Ma J. Zhang L. L. et al (2021). High-Efficiency Antibacterial and Anti-Mildew Properties Under Self-Assembly: An Environmentally Friendly Nanocomposite. Adv. Powder Technol.32, 2433–2440. 10.1016/j.apt.2021.05.018
41
Subba B. Rai G. B. Bhandary R. Parajuli P. Thapa N. Kandel D. R. et al (2024). Antifungal Activity of Zinc Oxide Nanoparticles (ZnO NPs) on Fusarium equiseti Phytopathogen Isolated from Tomato Plant in Nepal. Heliyon10 (22), e40198. 10.1016/j.heliyon.2024.e40198
42
Sukhodub L. Kumeda M. Sukhodub L. Vovchenko L. Prokopiuk V. Petrenko O. et al (2024). Effect of Zinc Oxide Micro- and Nanoparticles on Cytotoxicity, Antimicrobial Activity and Mechanical Properties of Apatite-Polymer Osteoplastic Material. J. Mech. Behav. Biomed. Mater.150, 106289. 10.1016/j.jmbbm.2023.106289
43
Thang N. Nguyen H. Van Huan V Phan D. N. Nguyen T. H. Nguyen T. M. L. (2023). Investigation of the Antimicrobial and Physico-Mechanical Properties of Nature-Friendly Nanosilver-Loaded Pig Lining Leather Prepared Using Exhaustion Method. Processes11, 1891. 10.3390/pr11071891
44
Vargas Hernández R. Alvarez Lemus M. A. De la Rosa García S. López González R. Quintana P. García Zaleta D. et al (2024). Antifungal Activity of ZnO Nanoparticles Synthesized from Eichhornia crassipes Extract for Construction Applications. Nanomaterials14 (12), 1007. 10.3390/nano14121007
45
Vo N. L. U. Van Nguyen T. T. Nguyen T. Nguyen P. A. Nguyen V. M. Nguyen N. H. et al (2020). Antibacterial Shoe Insole‐Coated CuO‐ZnO Nanocomposite Synthesized by the Sol‐Gel Technique. J. Nanomater.2020 (1), 8825567.
46
Wang Y. Qun M. Hanxiang J. Wang Z. (2016). One-Step Solution Synthesis and Formation Mechanism of Flower-Like Zno and Its Structural and Optical Characterization. Ceram. Int.42, 10751–10757. 10.1016/j.ceramint.2016.03.200
47
Zhang L. Ding Y. Povey M. York D. (2008). ZnO Nanofluids – A Potential Antibacterial Agent. Prog. Nat. Sci.18, 939–944. 10.1016/j.pnsc.2008.01.026
Summary
Keywords
antimicrobial coating, leather, modification, shoe lining, ZnO nanoparticles
Citation
Zheleva D, Angelova DS, Krumova E, Yovchevska L and Gocheva Y (2026) Investigation of ZnO Antimicrobial Surface Treatment of Shoe Lining Materials. Span. J. Soil Sci. 15:14992. doi: 10.3389/sjss.2025.14992
Received
30 May 2025
Revised
07 December 2025
Accepted
26 December 2025
Published
19 January 2026
Volume
15 - 2026
Edited by
Avelino Núñez-Delgado, University of Santiago de Compostela, Spain
Updates
Copyright
© 2026 Zheleva, Angelova, Krumova, Yovchevska and Gocheva.
This is an open-access article distributed under the terms of the Creative Commons Attribution License (CC BY). The use, distribution or reproduction in other forums is permitted, provided the original author(s) and the copyright owner(s) are credited and that the original publication in this journal is cited, in accordance with accepted academic practice. No use, distribution or reproduction is permitted which does not comply with these terms.
*Correspondence: Darina Zheleva, darinajeleva@abv.bg
Disclaimer
All claims expressed in this article are solely those of the authors and do not necessarily represent those of their affiliated organizations, or those of the publisher, the editors and the reviewers. Any product that may be evaluated in this article or claim that may be made by its manufacturer is not guaranteed or endorsed by the publisher.